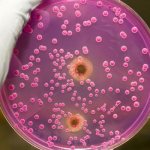
image

Что такое грибок кандида
Организм человека населен огромным количеством бактерий, которые помогают ему правильно функционировать. Когда нет проблем со здоровьем, все они находятся в балансе. Candida albicans – один из этих микроорганизмов – обитает в нормальной микрофлоре кишечника, на слизистой оболочке влагалища, полости рта. Так он выглядит на фото. Эти патогенные микроорганизмы:
- круглой формы;
- размером около 10 микрон;
- живут при температуре до 37 градусов;
- имеют стойкость к неблагоприятным условиям.
Когда по каким-либо причинам в организме происходит снижение иммунитета, начинается бурный рост дрожжевых грибков. Нормальная микрофлора при этом нарушается. Такая ситуация вызывает:
- развитие кандидоза – молочницы;
- поражение ногтей;
- распространение инфекции в полости рта;
- воспаление слизистых оболочек кишечника;
- заболевание органов дыхания, нервной системы.
Как передается
Главная опасность кандидоза – инфекция распространяется с большой скоростью. Кандида быстро поражает слизистые оболочки всего организма. Грибковое заболевание передается половым путем при незащищенном сексе. Возможно заражение через:
- продукты питания;
- постельное белье;
- предметы быта;
- плохо вымытые фрукты, овощи;
- поцелуи;
- игрушки;
- прокладки;
- предметы личной гигиены.
Дрожжеподобный грибок может попасть в организм при медицинском вмешательстве во время гинекологического, стоматологического осмотра с плохо обработанным инструментом. Кандида альбиканс передается:
- от женщины ребенку при родах;
- воздушно-капельным путем;
- новорожденным через плохо простиранные пеленки;
- при пользовании чужими предметами, одеждой.
Морфология и физиология грибка-паразита, или почему его трудно лечить?
Кандида Альбиканс — одноклеточный микроорганизм, размер которого составляет до 10 мкм. Размножается делением только в организме человека. Клетки овальные или круглые, имеющие плотную оболочку от 3 до 5 слоев. Может существовать в двух формах: дрожжевой, чтобы выживать в кислотных условиях, и грибковой — для развития в нейтральной и щелочной среде. Грибок устойчив к различным видам среды и температурным условиям, вплоть до высушивания и однократной заморозки. Однако он чувствителен к высоким температурам, солнечным лучам, йоду, фенолу, формалину и др. Обладает свойством активно адаптироваться, меняя свою форму, что помогает подстраиваться под изменения в организме человека. Это обеспечивает ему защиту при сопротивлении иммунной системы и воздействии лекарственных средств. Поэтому от него так не просто избавиться.
Симптомы кандидоза
Что такое кандидоз? Это инфекционное заболевание, спровоцированное быстрым размножением дрожжеподобных грибков. Патология сопровождается симптомами, зависящими от дислокации поражения. У больных кандидозом наблюдаются:
- грибок ногтей;
- поражения кожи;
- боли в мышцах;
- диарея;
- повышенное газообразование;
- заложенность носа;
- высыпания на оболочке ротовой полости;
- покраснения половых органов;
- головные боли.
- Мазь от грибка кожи
- Кожный грибок
- Грибок кожи
Грибковое заболевание кандидоз зачастую имеет симптомы, схожие с другими недугами:
- кандида в кишечнике провоцирует ухудшение аппетита, тяжесть в животе, вкрапления в стуле, похожие на творог;
- рост candida на поверхности кожи вызывает покраснения, папулы, пузырьки, эрозии;
- при оральном кандидозе присутствует белесый налет на поверхностях десен, щек, языка, трещины на губах.
У женщин
Патогенные микроорганизмы рода кандида воздействуют на слизистую влагалища, вызывая опасное и тяжелое заболевание. Что такое молочница у женщин? Это инфекция наружных и внутренних половых органов, вызванная патогенной микрофлорой, жизнедеятельностью грибка. Факторы, которые способствуют разрастанию кандида:
- отсутствие нормального иммунитета;
- аллергические заболевания;
- прием контрацептивов;
- употребление пищи, содержащей дрожжи, сахар;
- лечение антибиотиками вирусов;
- хронические заболевания ЖКТ;
- сахарный диабет.
Когда развивается молочница, у женщины наблюдаются такие признаки поражения кандида:
- боль и жжение во время секса;
- нарушения менструации;
- творожистые выделения из влагалища;
- болезненность при мочеиспускании;
- появление специфического кефирного запаха;
- снижение сексуального влечения;
- раздражение половых органов;
- болевые ощущения в тазовой области;
- бесплодие.
У мужчин
От активности грибка страдают и мужчины. Этому способствуют токсины, образующиеся как продукты жизнедеятельности бактерий. Кандида поражает кожу, воздействует на половые органы. У мужчин наблюдаются признаки молочницы, схожие с женскими симптомами:
- боли при мочеиспускании;
- появление сыпи, белесого налета на половом органе;
- образование папул.
Грибок рода кандида поражает кожу в области паха. О наличии инфекционного заболевания у мужчин свидетельствуют:
- воспаление, покраснение головки пениса;
- возникновение сыпи;
- образование пузырьков;
- болезненность при половом акте;
- нестерпимый зуд;
- ощущение жжение;
- развитие простатита;
- появление импотенции;
- снижение полового влечения.
Расшифровка мазков и нормы анализов
Чтобы анализы мазка были максимально достоверны, необходимо за сутки подготовиться к исследованию – нужно исключить половые контакты, не применять спринцевание и не использовать кремы, мази или свечи.
READ Когда и зачем берут мазок из уретры у мужчин?
Кроме того, рекомендуется не мочиться за два-три часа до взятия мазка.
Материал для анализа берется одноразовым шпателем и наносится на специальное стекло. Стекло отправляют для анализа в лабораторию, где его содержимое окрашивается и изучается с помощью микроскопа.
Взятие мазка, как правило, проходит безболезненно, но может сопровождаться неприятными ощущениями.
У женщин мазок берется из трех зон:
- из уретры;
- с шейки матки;
- из влагалища.
В анализе указываются результаты по исследованию всех точек.
У мужчин мазок берется только из уретры.
Во время исследования можно обнаружить:
- плоский эпителий;
- лейкоциты;
- грамположительные палочки;
- следы слизи;
- патогенные микроорганизмы и следы их активности (в том числе и псевдомицелий).
При расшифровке специалисты ориентируются на определенные нормы.
У женщин нормы чистоты влагалища поделены на 4 степени. Первая степень появляется только у здоровых женщин. В анализе подтверждается большое количество «нормальных» микроорганизмов и немного плоского эпителия.
Вторая степень допускает у женщин незначительное число кокков с преобладанием нормальной микрофлоры и тоже не является признаком развития патологии.
При третьей степени у женщин количество кокков значительно больше, кроме того, материал для анализа содержит лейкоциты (больше 10).
При четвертой степени полезная микрофлора у женщин практически уничтожена, а в анализе выявляется большое количество лейкоцитов и множественные следы инфекции.
Именно на третьей или на четвертых стадиях появляются нити псевдомицелия в мазке на флору.
Содержание мазка у беременных интерпретируется по тем же параметрам, что и у небеременных женщин. Кроме того, лейкоциты могут быть несколько выше нормы – до 15 – 20 в зоне видимости.
Процедура взятия мазка при беременности абсолютно безопасна для здоровья как плода, так и самой женщины.
READ Для чего берут мазок из зева и носа?
Классификация
При обнаружении псевдомицелий в анализах, в зависимости от скорости размножения грибков, тяжести недуга, различают виды кандидоза:
- поверхностный – начальная стадия – поддается лечению, патогенные бактерии действует ткани кожи, ногти, слизистую;
- системный вид – проникает в эпителий, способен поражать систему дыхания, органы пищеварения;
- сепсис – состояние, при котором кандида обнаруживается в крови, отравляет весь организм, не исключен летальный исход.
Существует классификация кандидоза в соответствии с формой грибкового заболевания:
- Острая – имеет ярко выраженные симптомы, при своевременной диагностике быстро вылечивается. В запущенном состоянии называется махровой, заражает эпителиальные ткани.
- Хроническая – появляется при неправильном лечении, отсутствии чувствительности к препаратам.
- Кандидоносительная – анализы показывают наличие огромного количества кандида без внешних проявлений болезни. Человек является носителем грибка, может заражать окружающих.
Причины появления повышенного количества грибов кандиды в мазке
Морфологические свойства дрожжевых микроорганизмов таковы, что дрожжи во влагалище продолжают мирное сосуществование с организмом человека до тех пор, пока не создана благоприятная среда для их размножения. Грибки в аномальном количестве появляются в период гормональных всплесков, сопровождающихся дефицитом или изобилием эстрогена (период полового созревания, беременность, климакс). Прием некоторых лекарственных препаратов провоцирует почкующиеся дрожжевые клетки. К ним относят:
- кортикостероидные препараты;
- антибиотики;
- гормональные средства контрацепции.
Заболевания, которые могут спровоцировать вторичный симптом в виде кандидоза:
- сахарный диабет;
- туберкулез;
- ЗППП:
- хламидиоз;
- трихомониаз;
- гонорея;
- генитальный герпес.
Внешние факторы, провоцирующие дрожжевые грибки в мазке:
- жаркий климат;
- тесное белье из ненатуральной ткани;
- ежедневные прокладки;
- нарушение микрофлоры влагалища путем частого спринцевания;
- несоблюдение личной гигиены;
- половой контакт с зараженным человеком.
Осложнения кандидоза
Если своевременно не заняться лечением инфекции, дрожжеподобные грибы кандида прорастают вглубь организма, поражают сосуды, попадают в кровь. После этого идет распространение патогенных микроорганизмов по всему организму. При этом наблюдается:
- появление новых очагов болезни;
- развитие кровотечений;
- нарушение половых функций;
- распространение инфекции на соседние органы.
Разрастание грибков при отсутствии лечения вызывает:
- прерывание беременности;
- заражение плода при родах;
- поражение органов пищеварения;
- возникновение аллергических реакций;
- нарушение работы почек;
- воспаление мочевого пузыря;
- бесплодие;
- появление спаек во влагалище;
- поражение шейки матки, провоцирующее рак;
- развитие гнойных инфекций;
- летальный исход.
- Грибок на руках
- Спринцевание при молочнице
- Грибок на коже
Причины появления
Прежде, чем начинать восстановление естественной флоры влагалища у женщин, важно установить причину развития патологии. Грибок Candida начинает активно размножаться под воздействием следующих факторов:
- сахарный диабет;
- слабый иммунитет;
- применение антибиотиков на основе микроорганизмов;
- туберкулез;
- гормональный сбой (снижается уровень эстрогена в организме у женщин);
- пренебрежение правилами гигиены;
- синтетическое нижнее белье;
- воспалительные заболевания, вызванные инфекцией;
- применение оральных контрацептивов.
Диагностика кандидоза
Существует более 150 разновидностей кандида. Правильное выявление возбудителя инфекции помогает быстро остановить разрастание грибков. Диагностика начинается с опроса больного, внешнего осмотра характерных признаков кандидоза. С целью определения инфекции используют метод исследования под микроскопом, при котором грибок candida хорошо виден. Для этого берут:
- мазок с места поражения;
- кусочки тканей кожи;
- пробы материала со слизистых оболочек.
Диагноз подтверждают, проводя культуральное исследование. Для выполнения анализа:
- делают забор биологического материала из зоны поражения;
- высеивают на питательную среду;
- по характеру разрастания колонии грибка определяют, наличие псевдомицелия, род кандида;
- специальные тест-системы выявляют чувствительность вида к лекарствам.
Анализ крови
Важную роль в диагностике играет исследование крови. Главная цель анализа – определение иммуноглобулинов. Их присутствие и вид характеризуют стадию болезни. Если при анализе крови обнаружили:
- Иммуноглобулин IgM – болезнь в острой форме, появилась недавно.
- Одновременное наличие IgM и IgG – длительность болезни больше недели. В организме образовались долговременные клетки иммунитета, противодействующие дальнейшему разрастанию грибков.
- Присутствие только IgG – свидетельство хронической патологии.
Диагностические мероприятия
Как лечить Кандида Альбиканс расскажет доктор. При характерных признаках необходимо пройти диагностику, по результатам которой рекомендуется соответствующая терапия. Существует много методов лабораторных исследований.
Ломексин о грибка и инструкция по его применению
Наиболее информативные способы диагностики:
- Анализ материала, изъятого их конкретного локуса – влагалище, уретра, ротовая полость и т.д. Соскоб окрашивается, фиксируется, изучается посредством многократного увеличения (применяют современные микроскопы);
- ПЦР либо полимерная цепная реакция предстает наиболее чувствительным анализом для обнаружения инфекции грибкового характера. Если в биологической жидкости человека – урина, слюна либо кровь, обнаружены ДНК вредителя, то говорят о положительном результате. Требуется соответствующее лечение Кандида альбиканс;
- Анализ иммуноферментный обнаруживает lgG либо М к Кандида альбиканс. На фоне исследования ИФА и ПЦР нормой принято считать отсутствие ДНК либо антител именно к этому возбудителю;
- Исследование серологического характера при выявлении наличия антител в крови свидетельствует о патологическом процессе в организме;
- Аллергический способ исследования подразумевает осуществление внутрикожных уколов, являющихся аллергенами паразитов.
Обязательно проводится бактериологический анализ, позволяющий выявить конкретного паразита, определить его восприимчивость к лекарствам противогрибковой природы. Эта процедура позволяет ответить на вопрос, чем лечить в определенной клинической картине.
Важно: у здорового человека количество Candida albicans не должно превышать 10 в 4 степени КОЕ/мл. Если анализ показал 10 в 5 степени, либо 10 в 6, то требуется срочное лечение.
Содержание Кандида альбиканс в урине, слюне и кале в норме составляется 10 в 3 степени КОЕ/мл.
Лечение
Чтобы вывести грибок, необходимо поднять иммунитет, вылечить хронические заболевания, ослабляющие защитные силы. Важную роль играет восстановление нормальной микрофлоры организма. Как лечить кандидоз? Врачи назначают:
- иммуномодуляторы;
- витамины С, группы В;
- для местного применения – антимикотические вагинальные свечи, мази;
- внутрь – противогрибковые капсулы, таблетки;
- правильное питание;
- ограничение половых контактов;
- дезинфекцию белья;
- выполнение гигиенических процедур;
- лечение полового партнера.
Что убивает кандиду в организме
Чтобы организму избавиться от инфекции, необходимо воздействовать на грибок. Справиться с патологией помогают лекарства с фунгицидным эффектом, которые повреждают бактерии и споры микроорганизмов. Дерматологи назначают:
- внутрь влагалища – свечи Ливарол, Ломексин;
- для наружной обработки – мазь Клотримазол, крем Тридерм;
- если обнаружен грибок ногтей – Фунготербин, Дифлюкан;
- при поражении стенок кишечника, органов дыхания – внутрь таблетки Флуконазол, Нистатин.
Лекарства
При наличии заболевания, когда причина инфекции – грибок, терапия предполагает применения лекарственных препаратов. Их действие решает различные проблемы. Врачи выписывают:
- Кандид – действующее вещество клотримазол, выпускается в форме крема, порошка, раствора, лечит грибок на коже, половых органах, во рту;
- Пимафуцин – имеет антигрибковое и противовирусное действие, эффективен при молочнице;
- Линекс – пробиотик, восстанавливает микрофлору, баланс бактерий;
- Виферон – активизирует иммунитет, препятствует делению клеток.
Продукты питания
Чтобы истребить грибок в организме, необходимо правильно питаться. Следует больше употреблять листовой зелени, чечевицы, фасоли. Есть капусту, кабачки, болгарский перец, свежие фрукты. Необходимо исключить продукты, вызывающие брожение, содержащие дрожжи и вещества, провоцирующие грибок:
- рафинированный сахар;
- выпечку из дрожжевого теста;
- маринованные заготовки;
- вино;
- пиво;
- уксус;
- соусы;
- грибы;
- копченую рыбу;
- фруктовые соки;
- виноград.
Куда нужно обращаться?
Молочница является наиболее распространенной инфекцией половых органов. Поэтому анализы на определение заболевания проводятся давно, и определить кандидоз не составляет труда. При подозрении на молочницу пациенты в большинстве своем обращаются в обычную больницу. К слову, можно сделать исследование и в частной клинике.
По наблюдениям пациентов, лучше всего сдавать биоматериал там, где работает лечащий врач – связь с лабораторией быстрая, нет необходимости ездить в разные места за результатами, а в частных клиниках и вовсе результат при повторном посещении будет уже в кабинете у доктора.
Лечение грибка кандида народными средствами
При комплексном лечении грибковой инфекции используются народные рецепты. Важно, чтобы применение было согласовано с врачом и проходило после диагностики. Рекомендуют пить по ложке в день отвар корня полыни – 20 г листьев на стакан кипятка. Широкое применение имеет сода – щелочная среда разрушает грибок. На литр кипяченой воды добавляют одну ложку. Применяют:
- в виде ванночек ежедневно при кандидозе на половом члене;
- как примочки по несколько раз за сутки – при грибке во рту;
- при молочнице у женщин – для спринцеваний через день.
Заболевания, вызванные Candida albicans
Кандида альбиканс вызывает множество заболеваний, поражающих отдельные органы и системы.
Вагинальный кандидоз
Вагинальный кандидоз возникает, когда грибковые штаммы колонизируют влагалище. Болезнь основана на всех серьезных гинекологических проблемах, включая бесплодие. Это затрагивает в основном женщин детородного возраста, а у беременных женщин риск вагинального кандидоза отскакивает в 2-3 раза.
Развитие этой патологии стимулируется снижением не только полного иммунитета, но и дисбалансом бактерий во влагалищной микрофлоре.
Типичным симптомом заболевания являются сильный зуд, который усугубляется, особенно после душа, интимного контакта и физической активности.
Чувство жгучего зуда увеличивается во время цикла у женщин. Влагалище становится беловато-серого цвета, имеет неприятный запах.
Эти характерные симптомы отсутствуют в хронической форме заболевания. Затем происходит атрофия подкладки и сужение входа во влагалище.
Не вылеченный вагинальный кандидоз вызывает уретрит, вульвовагинит, бесплодие, выкидыши, преждевременные роды и эндометриоз, возникающие в послеродовом периоде.
Молочница во рту
Кандидоз во рту является еще одним неприятным заболеванием, вызванным Candida albicans.
Патология также известна под названием молочницы. Она протекает с выраженным болезненным симптомом, который возникает вслед за появлением налета (язык, внутренняя часть щеки, внутренняя часть губ, десны).
Не исключено развитие стоматита. Пациенты жалуются на проблемы с деснами и неприятный запах изо рта.
Болезнь Хашимото
Хашимото является одним из заболеваний, вызванных candida albicans. Патологический рост грибковых дрожжей также влияет на щитовидную железу. Синдром Хашимото, связанный с нарушенной эндокринной функцией, также может быть вызван грибком.
Через кровоток, он достигает железы и отрицательно влияет на ее функцию. Candida albicans буквально превращает наше тело в раба. Все функции в нем регулируются потребностями гриба для роста и развития.
Хашимото принадлежит к числу неизлечимых болезней. Все пациенты с этим диагнозом становятся узниками заболевания и принимают пожизненные лекарства.
Другие болезни
Постоянные грибки Candida albicans, которые паразитируют в нашем организме, ответственны за различные заболевания.
Но, к сожалению, врачи редко направляют свое внимание на этот патоген и предписывают схемы лечения симптомов, а не происхождения заболевания.
Таким образом, сотни тысяч пациентов с Кандида альбиканс не знают чем больны и соответственно не лечатся. В результате ухудшается их состояние и появляется больше жалоб и болезней.
У детей болезнь может привести к умственной отсталости и проблемам памяти у взрослых.
Часто грибковый паразит отвечает за болезни сердца и легких. Некоторые эксперты говорят, что это причина рака.
Профилактика
Чтобы исключить грибковую инфекцию, необходимо проведение профилактических мероприятий. Это поможет избежать рецидива после успешного исцеления. Требуется соблюдать правила:
- избегать половых актов во время лечения;
- выполнять правила гигиены;
- поддерживать иммунитет;
- вовремя лечить хронические болезни;
- иметь секс с постоянным партнером;
- придерживаться правильного рациона;
- пользоваться натуральным бельем;
- избегать переохлаждения;
- отказаться от курения;
- избегать стрессов.